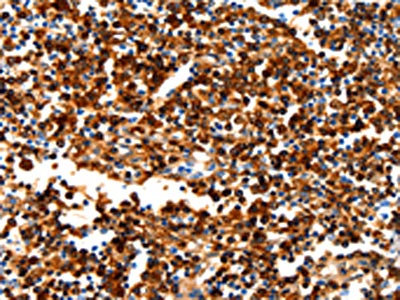

NCOR1 Antibody
-
中文名稱:NCOR1兔多克隆抗體
-
貨號(hào):CSB-PA980423
-
規(guī)格:¥1100
-
圖片:
-
The image on the left is immunohistochemistry of paraffin-embedded Human cervical cancer tissue using CSB-PA980423(NCOR1 Antibody) at dilution 1/100, on the right is treated with synthetic peptide. (Original magnification: ×200)
-
The image on the left is immunohistochemistry of paraffin-embedded Human tonsil tissue using CSB-PA980423(NCOR1 Antibody) at dilution 1/100, on the right is treated with synthetic peptide. (Original magnification: ×200)
-
-
其他:
產(chǎn)品詳情
-
Uniprot No.:
-
基因名:
-
別名:hN CoR antibody; hNCoR antibody; KIAA1047 antibody; N CoR antibody; N Cor/SMRT corepressor Rip13 antibody; N CoR1 antibody; N-CoR antibody; N-CoR1 antibody; NCOR 1 antibody; NCoR antibody; Ncor1 antibody; NCOR1_HUMAN antibody; Nuclear receptor co repressor 1 antibody; Nuclear receptor corepressor 1 antibody; Retinoid X receptor interacting protein 13 antibody; RIP13 antibody; Rxrip13 antibody; thyroid hormone and retinoic acid receptor associated corepressor 1 antibody; TRAC 1 antibody; TRAC1 antibody
-
宿主:Rabbit
-
反應(yīng)種屬:Human
-
免疫原:Synthetic peptide of Human NCOR1
-
免疫原種屬:Homo sapiens (Human)
-
標(biāo)記方式:Non-conjugated
-
抗體亞型:IgG
-
純化方式:Antigen affinity purification
-
濃度:It differs from different batches. Please contact us to confirm it.
-
保存緩沖液:-20°C, pH7.4 PBS, 0.05% NaN3, 40% Glycerol
-
產(chǎn)品提供形式:Liquid
-
應(yīng)用范圍:ELISA,IHC
-
推薦稀釋比:
Application Recommended Dilution ELISA 1:2000-1:10000 IHC 1:100-1:300 -
Protocols:
-
儲(chǔ)存條件:Upon receipt, store at -20°C or -80°C. Avoid repeated freeze.
-
貨期:Basically, we can dispatch the products out in 1-3 working days after receiving your orders. Delivery time maybe differs from different purchasing way or location, please kindly consult your local distributors for specific delivery time.
-
用途:For Research Use Only. Not for use in diagnostic or therapeutic procedures.
相關(guān)產(chǎn)品
靶點(diǎn)詳情
-
功能:Mediates transcriptional repression by certain nuclear receptors. Part of a complex which promotes histone deacetylation and the formation of repressive chromatin structures which may impede the access of basal transcription factors. Participates in the transcriptional repressor activity produced by BCL6. Recruited by ZBTB7A to the androgen response elements/ARE on target genes, negatively regulates androgen receptor signaling and androgen-induced cell proliferation. Mediates the NR1D1-dependent repression and circadian regulation of TSHB expression. The NCOR1-HDAC3 complex regulates the circadian expression of the core clock gene ARTNL/BMAL1 and the genes involved in lipid metabolism in the liver.
-
基因功能參考文獻(xiàn):
- verexpression of COPS5, through its isopeptidase activity, leads to ubiquitination and proteasome-mediated degradation of NCoR, a key corepressor for ERalpha and tamoxifen-mediated suppression of ERalpha target genes. PMID: 27375289
- Authors previously shown that Nuclear Receptor Corepressor 1 (NCoR) and the thyroid hormone receptor beta1 (TRbeta) inhibit tumor invasion. Here they show that these molecules repress VEGF-C and VEGF-D gene transcription in breast cancer cells, reducing lymphatic vessel density and sentinel lymph node invasion in tumor xenografts. PMID: 27806339
- Nuclear Receptor Corepressor 1 is an important transcriptional regulator that interacts with nuclear receptors and other transcription factors. Recent results have shown the presence of inactivating mutations or deletions of the nuclear receptor corepressor 1 gene in human tumors. PMID: 27149915
- NCOR1 function declines with prostate cancer progression. Reduction in NCOR1 levels causes bicalutamide resistance in LNCaP cells and compromises response to bicalutamide in mouse prostate in vivo PMID: 26968201
- USP44 contributes to N-CoR functions in regulating gene expression and is required for efficient invasiveness of triple-negative breast cancer cells. PMID: 27880911
- PDCD2 and NCoR1 may act as tumor suppressors in Gastrointestinal stromal tumors cells through the Smad signaling pathway. PMID: 26589942
- NCoR depletion enhances cancer cell invasion and increases tumor growth and metastatic potential. PMID: 26729869
- loss of nuclear NCoR results in upregulation of a specific cancer-related genetic signature, and is significantly associated with malignant melanoma progression. PMID: 25823659
- The co-localization of AML1-ETO with the N-CoR co-repressor to be primarily on genomic regions distal to transcriptional start sites. (NcoR1) PMID: 25928846
- Data suggest that direct interactions of HLCS (holocarboxylase synthetase) with NCOR1 (nuclear receptor corepressor 1) and HDAC1 (histone deacetylase 1) contribute toward transcriptional repression of repeats, presumably increasing genome stability. PMID: 24840043
- Low NCoR expression is associated with glioblastoma. PMID: 24335696
- Site directed mutagenic analysis of N-CoR identified serine 1450 as the crucial residue whose phosphorylation by Akt was essential for the misfolding and loss of N-CoR protein. PMID: 23940660
- Study shows that NCoR1 is a key target of proteolysis and physically interacts with the transcription factor CREB, the genome-wide map described here ties proteolysis in mammalian cells to active enhancers and to promoters of specific gene families. PMID: 24315104
- The aberrant cytoplasmic expression of NCoR1 in retinoblastoma appears to be associated with the proliferative and/or dedifferentiated properties of retinoblastoma. PMID: 23295231
- Corepressor molecules NCoR and SMRT are present at 1,25(OH)2D3 activated gene enhancers PMID: 22944139
- NCOR1 and HDAC3 are instrumental in the repression of glucocorticoid receptor gene transcription. PMID: 23428870
- These results uncover a regulatory mechanism by which PKA positively modulates NCoR function in transcriptional regulation in prostate cancer. PMID: 23129261
- CK2alpha-NCoR cascade selectively represses the transcription of IP-10 and promotes oncogenic signaling in human esophageal cancer cells. PMID: 22675025
- A novel mechanism by which overexpression of estrogen receptor (ER) beta through NCoR is able to down regulate ER alpha gene expression, thus blocking ER alpha's driving role on breast cancer cell growth. PMID: 22622808
- Findings suggest that N-CoR-induced repression of Flt3 might be crucial for limiting the contribution of the Flt3 signaling pathway on the growth potential of leukemic cells. PMID: 22514634
- Regulated HDAC3 degradation serves as a buffering mechanism to protect independent formation of N-CoR and SMRT corepressor complexes. PMID: 22337871
- Data suggest a possible role of misfolded N-CoR protein in the activation of oncogenic survival pathway in non-small cell lung cancer cells. PMID: 21966475
- ERbeta and its co-regulators p300 and NCoR are expressed in human transitional cell bladder cancer PMID: 21525722
- the aberrant recruitment of NCOR1 by TRbeta mutants leads to clinical resistance to thyroid hormone (RTH) PMID: 21987803
- Differential interaction of NCoR1 with TR isoforms accounted for the TR isoformdependent regulation of adipogenesis and that aberrant interaction of NCoR1 with TR could underlie the pathogenesis of lipid disorders in hypothyroidism. PMID: 21389087
- data strongly support a model in which EBNA2 association with NCoR-deficient RBPJ enhances transcription and EBNALP dismisses NCoR and RBPJ repressive complexes from enhancers PMID: 21518914
- These data support the hypothesis that NCoR might control a cell cycle dependent regulation of expression androgen receptor target genes in prostate cells. PMID: 20974212
- Aberrant corepressor interactions implicated in PML-RAR(alpha) and PLZF-RAR(alpha) leukemogenesis reflect an altered recruitment and release of specific NCoR and SMRT splice variants. PMID: 21131350
- Amino-terminal A/B domain deletion facilitated the in vitro binding of nuclear receptor CoR with wild-type PPARG2. PMID: 20587609
- Elevated NCOR1 disrupts PPARalpha/gamma signaling and is associated with prostate cancer. PMID: 20466759
- This paper describes the cloning of the full-length human NCOR1 cDNA. PMID: 9724795
- The authors established an interaction of E8;E2C with an NCoR1/HDAC3 complex and demonstrated that this interaction requires the wild-type E8 open reading frame. PMID: 20181716
- NCOR1 protein expression level predicts response to endocrine therapy as first-line treatment for breast cancer patients on relapse. PMID: 19781322
- Nuclear receptor corepressor-dependent repression of peroxisome-proliferator-activated receptor delta-mediated transactivation PMID: 11903058
- These results demonstrate that AR, in contrast to other SHRs, is regulated by NCoR PMID: 12089345
- Exchange of N-CoR corepressor and Tip60 coactivator complexes links gene expression by NF-kappaB and beta-amyloid precursor protein. PMID: 12150997
- recruited by prohibitin for transcriptional repression PMID: 12466959
- N-CoR functions not merely as a repressor of basal transcription, but rather as a modulator of both basal and ligand-activated transcription of genes controlled by RAR/RXR heterodimers in a dose-dependent manner PMID: 12648520
- associates with CHD1 and histone deacetylase as well as with RNA splicing proteins PMID: 12890497
- N-CoR utilizes repression domains I and III for interaction and co-repression with ETO PMID: 15377655
- NCoR is a physiological regulator of the AR; the N-terminal surface of the AR-mediating NCoR recruitment was distinct from tau5 and from the FXXLF motif that mediates agonist-induced N-C-terminal interaction PMID: 15598662
- the DAD domain of N-CoR is singularly essential for repression by the thyroid hormone receptor PMID: 15695367
- N-CoR and SMRT play an active role in preventing tamoxifen from stimulating proliferation in breast cancer cells through repression of a subset of target genes involved in ERalpha function and cell proliferation PMID: 15802375
- N-CoR together with JMJD2A could play a role in repressing achaete scute-like homologue 2 (ASCL2) expression in various tissues. PMID: 16024779
- mechanism by which the estrogen-ER complex markedly reduces the level of N-CoR through a process involving the up-regulation of Siah2 and the subsequent targeting of N-CoR for proteasomal degradation PMID: 16141343
- SAFB1 was shown to interact directly with the nuclear receptor corepressor N-CoR. PMID: 16195251
- N-CoR and TRbeta cooperate in the regulation of the TSHbeta gene and this ligand-dependent repression is mediated by the LXXLL motif in N-CoR PMID: 16216492
- SMRT and N-CoR corepressors are involved in transcriptional regulation by both agonist- and antagonist-bound AR and regulate the magnitude of hormone response, at least in part, by competing with coactivators. PMID: 16373395
- Results provide evidence to show that the N-CoR/HDAC3 co-repressor complex is involved in the aberrant transcription regulation in PML-RARalpha-expressing cells. PMID: 16730330
- RB7 and butyrate induce dissociation of HDAC3 (but not HDAC1 or HDAC2) and its adaptor protein NCoR. PMID: 16849648
顯示更多
收起更多
-
亞細(xì)胞定位:Nucleus.
-
蛋白家族:N-CoR nuclear receptor corepressors family
-
數(shù)據(jù)庫(kù)鏈接:
Most popular with customers
-
YWHAB Recombinant Monoclonal Antibody
Applications: ELISA, WB, IHC, IF, FC
Species Reactivity: Human, Mouse, Rat
-
-
-
-
-
-
-
VDAC1 Recombinant Monoclonal Antibody
Applications: ELISA, WB, IHC
Species Reactivity: Human, Mouse, Rat